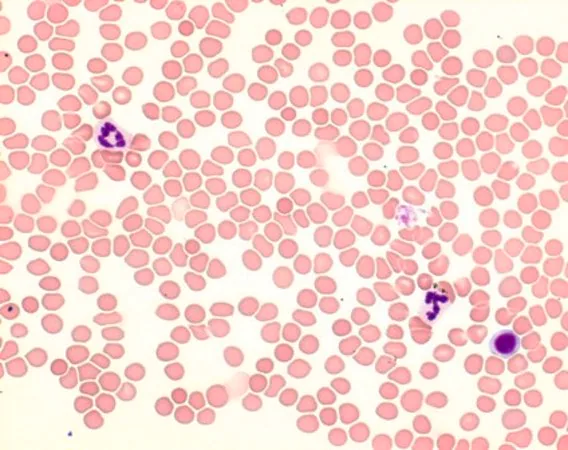

-
- Медицински консумативи
- Общ болничен консуматив
Реактив на Гимза еозин метиленово синьо за микроскопия
 Продуктите се доставят в срок от 2-5 дни за територията на България
Продуктите се доставят в срок от 2-5 дни за територията на България
Реактив на Гимза еозин метиленово синьо за микроскопия
109204
MERCK
Разтворът на Giemsa Azure Eosin Methylene Blue - за микроскопия, може да се използва за оцветяване на кръвни и костно-мозъчни натривки, парафинови срези и клинично-цитологични проби. Оцветяването по Giemsa е една от стандартните процедури в хистологията, която демонстрира различни клетки с техните морфологични характеристики по-добре, отколкото с H&E оцветяване. Когато се използва в хематологични приложения, оцветяването по Giemsa често се използва в комбинация с други оцветяващи разтвори, например с разтвор на May-Grünwald за общо оцветяване по Pappenheim (MGG). Този готов за употреба оцветяващ разтвор обикновено оцветява ядрата в червено, въз основа на молекулярното взаимодействие между багрилото еозин Y и Azure B-DNA комплекс. И двете багрила се сглобяват в Eosin Y - Azure B-DNA комплекс и интензитетът на полученото оцветяване зависи от съдържанието на Azure B и съотношението Azure B : Eosin Y. Освен това, полученото оцветяване може да варира в зависимост от влиянието на фиксацията, времето за оцветяване, pH-стойността на разтворите или буферните вещества. В хистологията и клиникоцитологичните приложения, оцветяването по Гимза без допълнителни оцветявания се използва като метод за разширено общо оцветяване. При този метод цветът на различните клетъчни компоненти се влияе от предварителната обработка на материала на пробата. Тук структурите, съдържащи хроматин (напр. клетъчни ядра), се появяват в различни сини нюанси, докато ацидофилните компоненти се появяват в различни червени нюанси. Бутилката от 500 мл е достатъчна за 3500-5000 оцветявания. Този продукт е регистриран като IVD и е маркиран с CE.

Медицинско изделие за инвитро диатностика

Стерилно медицинско изделие - Умерен риск

Лесно запалимо

Остра токсичност

Канцерогенност
Подобни продукти
Често задавани Въпроси!
Първо опитайте с търсачката, като въведете дума или каталожен номер. В случай, че не намирате желания продукт, изберете желаната категория и разгледайте продуктите в нея. Възможно е вашият продукт да е заведен с друго търговско име. След като изберете желания продукт, трябва да зададете параметрите по които искате да бъде дефиниран той, в случай че този продукт има разновидности. Изберете обем или размери, за да ви излезе цената. Вече може те да натиснете "поръчай" .
За да видите цената на желания от вас продукт, първо трябва да посочите обем, размери или други параметри, които се отнасят за него. Когато един продукт има няколко разновидности, първоначално се показват чертички в цената, защото не може да излязат едновременно всички цени на отделните видове от този артикул. След избора ви на параметър, цената става видима за съответния вид.
Този казус е валиден само при поръчка на химически реагенти, които не могат да се изпращат по куриерска служба, която няма лиценз за транспортиране на опасни товари, каквите са самите реагенти. Отказът ни да се изпращат химикали по Еконт или Спиди е защото самите куриери отказват да вземат такива товари, поради липса на АДР. Затова такива поръчки се изпълняват чрез Транспрес или друга спедиторска фирма, отговаряща за изискванията.







 English
English Назад
Назад